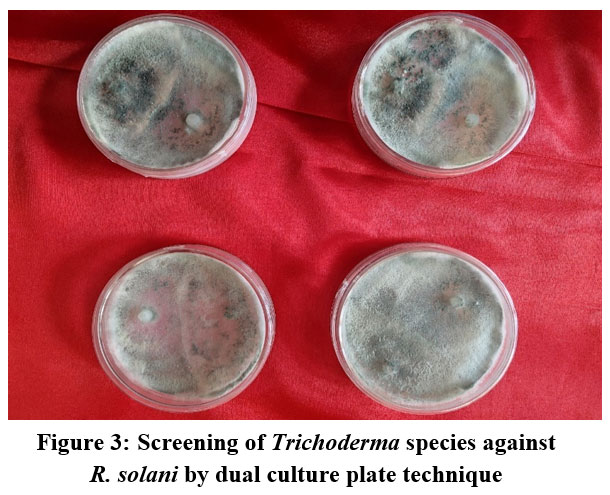

Introduction
The corn plant is a self pollinated as well as cross pollinated monoecious plant. It is greatest gift to humanity. Corn is originated in Guatemala and Southern Mexico where Indians cultivated in for many centuries before Whitman stepped on this land. In India Corn production began sometime during 17th century introduced by East India Company. Corn is the third most important food crops after rice and wheat in India. It contributes nearly 9 % in the national food basket. Sheath blight disease of corn reduces crop grain yield in several Asian countries.1 There are several methods have been suggested to control this disease such as cultural, chemical and biological. Use of cultural and chemical control methods are time taking and not sufficiently efficacious. Also it is harmful to the beneficial microbes in the soil which creates residual problems.2 So, biological concept was put forward.3 Among different fungal diseases that affects corn production, sheath blight proves more serious disease as grain losses ranges from 11 – 40% on some cultivars in some warm and humid regions, where the conditions are favourable for the causal agent grain losses were reported even upto 100%.4-6 In different districts of Uttar Pradesh efficacious management of sheath blight disease of corn is possible only when the causal organism is eliminated completely or the propagules are below economic entrance confine at field level. Control measures were used partly efficient because R. solani produces sclerotia that can continue / persist in the soil for at least two years.7 Carbendazim, neem oil, and T. harzianum were evaluated as seed treatment with spray in various combinations for disease management.8 Treatments that included both seed treatment and spray application proved to be more effective than seed treatment alone. In present investigation bio-control and botanicals methods are used as it has less human health risks, selective mode of action, improved soil conditions, lack of activity against most beneficial microbes and agricultural sustainability. So, this method can be very effective to use for the sheath blight disease of Zea-mays control as the bio – agent multiply in soil and offer protection throughout the crop development. Now the disease is gaining the economic importance in Uttar Pradesh.
Materials and methods
The present work was carried out in the year 2022-23 at the Department of Botany, K. N. Govt. P.G College, Gyanpur, Bhadohi, U. P., India. Complete randomized design with three replications were used for in vitro experiments. Five fungicides viz., Bavistin, Captan, Propiconozole, Mancozeb, Metalaxyl at concentrations of 10, 20 and 30 ppm were evaluated against R. solani isolated from diseased plant part. Plates without any treatment was served as control. For each treatment three replications were used and after 96 hours of inoculation data were recorded.
Percent inhibition of mycelial growth calculated using the following formula-
I = C-T / T X 100,
Where,
I = Per cent inhibition of mycelial growth
C = Colony diameter in control (mm)
T = Colony diameter treatment (mm).
Treatment with botanicals were done by well plate method and twelve species of Trichoderma were evaluated against R. solani. After 96 hours of incubation, radial growth of the test fungus as well as bio-agent was measured to determine the antagonistic capability of the bio-agents.
For field performance assessment, the trials were conducted in randomized block design with three replications which maintain spacing of 60 cm between rows and 20 cm between plants. Firstly the plant were made sick by by inserting 3-4 fully colonized maize grains with R. solani between the rinds and the enclosing sheaths at second or third basal internodes of 35- 45 days old test plants. The population level of Trichoderma strains in each soil inoculum was maintained at 106 cfu g-1 dry soils by mixing acid washed and sterilized sand. After treating with fungicides, maize seeds were air dried before sowing. Spray mode was used to apply botanicals and bio-agents on the aboveground parts of maize plants. Spray of only neem oil and water served as check.
Results
Table-1 showed the result of the evaluation of fungicides against mycelia growth of pathogen. Observation table showed that among five fungicides, Bavistin showed maximum percent of inhibition i.e. hundred percent (100%) at 10 ppm concentration followed by Propiconazol (84.2%) > Mancozeb (81.3%) > Metalaxyl (69.4%). At increasing concentration of fungicides each one showed increased percentage (%) of inhibition of mycelia growth.
Table 1: Poison food technique for evaluation of fungicides against R. solani (mycelial growth inhibition %).
| Concentration | Bavistin | Captan | Propiconazole | Mancozeb | Metalaxyl | Control |
| 10ppm | 100 ± Ec | 75.5 ± Cc | 84.2 ± Ac | 81.3 ± Bc | 69.4 ± Dc | 0 ± F |
| 20ppm | 100 ± Eb | 76.7 ± Cb | 85.1 ± Ab | 80.7 ± Bb | 69.8 ± Db | 0 ± F |
| 30ppm | 100 ± Ea | 80.4 ± Ca | 85.1 ± Aa | 80.7 ± Ba | 69.8 ± Da | 0 ± F |
The results of colony interactions have been presented in Fig: 1. Seven strains of Trichoderma species showed more efficiency in inhibiting the growth of R. solani in vitro. The order of their effectiveness were T. harzianum >T. virens > T. viride> T. koningi> T. alni > T. atrovirideae and T.longibrachiatum. The results showed that Trichoderma harzianum exhibited maximum inhibition of R. solani (80%) followed by T. virens (74%) and T. viride (72%).
![]() |
Figure 1: Screening of different strains of Trichoderma spp. against R. solani. |
The data from Fig:2 indicate that with different treatment the mycelial growth inhibition varied significantly. Maximum inhibition of (94%) per cent of mycelial growth was recorded in Azadirachta indica oil (nimbicidin) at (6%) per cent concentration which was significantly superior to all other nine treatments followed by clove oil.
![]() |
Figure 2: Efficacy of different botanicals on growth of R. solani. |
The effect of seed treatment with most effective botanicals, chemical and bio-agents were on percent disease index were also studied. The observation made from table 2 revealed that statistically significant differences among the treatments for Percent Disease Index (PDI). In S1treatment seeds treated with T. harzianum @ 5g/500gm showed maximum PDI i.e. 30.4% whereas in S2 treatment when seeds were treated with Bavistin 50WP @ 1.625 g/500gm, PDI was of 2.3 %. In S3 seed treatments PDI was noted 38.4% applying neem oil @ 5ppm/500ml. The S4 seed treatments i.e control PDI was recorded 93.6%. The S5 seed treatment showed more or less equivalent PDI as Bavistin (2.8 and 2.3 respectively).
Table 2: Effect of seed treatment with most effective botanicals, chemicals and bio-agents on percent disease index
| Sr. No. | Treatment | Percent disease index (PDI) |
| 1 | S1 | 30.4 ± 0.3 |
| 2 | S2 | 2.3 ± 0.2 |
| 3 | S3 | 21.2 ± 0.22 |
| 4 | S4 | 93.6 ± 0.3 |
| 5 | S5 | 2.8 ± 0.3 |
| 6 | S6 | 2.9 ± 0.5 |
| 7 | S7 | 4.6 ± 0.65 |
S1= T. harzianum@ 5g/500gm, S2 = Bavistin 50 WP @ 1.625 g/500gm,
S3 = Neem Oil 5ppm/500ml, S4 = Control, S5 = T. harzianum + Bavistin
S6 = Bavistin + Neem Oil, S7 = T. harzianum + Neem Oil
Different combinations were used to assess the possibility of control of disease during field experiment which was conducted during Kharif (rainfed) season of 2022-23.Table 5 showed the evaluation of foliar spray with botanicals, chemicals and antagonists on grain yield. The maximum disease control was reported when T. harzianum applied @ 5 g/500gm with foliar spray of neem oil in S1 treatment (90.9%) followed by seed treatment with chemical Bavistin 50WP @ 1.625/500 gm with foliar spray of neem oil in S2 treatment, whereas in S3, seed treatment with foliar spray both of neem oil the disease control was recorded 75.9%. The minimum disease control was noted when seed treatment and foliar spray both done by neem oil (75.9%).
Table 3: Effect of seed treatment and foliar spray with botanicals, chemicals (Bavistin) and bio-agents on grain yield.
| Grain Yield (q/hectare) | |||||
| Sr. No. | Foliar Spray | Seed Treatment | |||
| S1 | S2 | S3 | |||
| 1 | F1 | Neem Oil | 90.9 | 80.3 | 75.9 |
| 2 | F2 | Control | 70.6 | 74.6 | 60.6 |
S1 = T. harzianum @ 5g/500gm, S2 = Bavistin 50WP 1.625/500gm, S3 = Neem oil @5ppm/500ml
F1 = Neem oil, F2 = Control
Discussion
Absence of resistant cultivars lead the use of fungicides to control sheath blight in practice. In this investigation, five fungicides were used for their effect on mycelial growth of R. solani i.e. Bavistin 50% WP, Captan 70%, propiconazole 25% EC, Mancozeb 75% WP, Metalaxyl 72%WP. Result presented in table 1 showed that all fungicides significantly inhibited mycelial growth of R. solani as compare to the control at all the test concentration viz. 10, 20 and 30 ppm . The result clears that among five fungicides, Bavistin showed maximum percent of inhibition i.e. hundred percent (100%) at 10 ppm concentration followed by Propiconazol (84.2%) > Mancozeb (81.3%) > Metalaxyl (69.4%). At increasing concentration of fungicides each one showed increased percentage (%) of inhibition of mycelial growth.
These results showed similarity with the work done by9 who reported that Propiconazole @5.2 X 10-2 μg a.i. ml-1very effective against Rhizoctonia solani in in vitro condition.10 reported that Carbendazim was most effective chemical for Rhizoctonia bataticola. 11-12 also observed the similar results. In the present investigation foliar spray with Bavistin (Carbendazim) 50% WP, was found effective in reducing the severity of sheath blight disease of maize.
Generally for control of phytopathogenic fungi, systematic fungicides were used. In recent years awareness regarding toxic hazards of chemicals to crop consumers and environment has been increased. So, the importance of indigenous plant products in plant disease control has been emphasized. In the present study, investigations were carried out to evaluate indigenous plant extracts (botanicals) for the possible presence of fungitoxic substances against Rhizoctonia solani f.sp. sasakii in vitro and management of the disease. Out of nine essential oil tested against R. solani for their fungicidal activity, Neem oil showed strong fungicidal property and its fungitoxic activity may be due to the presence of azadirachtin13. Respectively, by applying of neem oil as seed treatment and adding spray which is most effecting and eco-friendly technique in controlling this disease.8,14-15
Trichoderma is an effective biocontrol agent of Sclerotium rolfsii, Rhizoctonia solani and Pythium aphanidermatum.16-17 There are only few reports of its effectiveness as a biocontrol agent controlling Sheath Blight disease of Corn caused by R. solani. Therefore, an attempt has been made to manage leaf sheath blight (LSB) disease of corn through Trichoderma species. Screening is an important step in the development of bio-control agents. Screening procedure helps to identify an appropriate candidate and the success of all subsequent stages depends on it.18-19 The screening by dual culture involve mostly interaction studies and potential antagonists identified on that basis ranked according to their ability to inhibit the growth of the pathogen20,21 studied the interaction between pathogens and antagonists in dual culture on PDA media, by measuring the percent inhibition of growth. The present investigation is an important study regarding the possibility of controlling / managing this disease by screening with bio agents Trichoderma spp. in dual culture. The data of dual culture assay showed that all 12 Trichoderma spp. strains tested significantly differed from the control in relation to growth diameter of R. solani (Fig-1 and 3). On agar media, different inhibition zones were produced by the interaction of the antagonists and the pathogen which could be considered as a result of the production of antibiotics, cell wall degrading enzymes and competition for nutrients and space.22 However, T. harzianum isolate showed higher growth inhibition of R. solani (80%) compared to the other isolates. Fig. 4 showed the faster growth of antagonist over pathogen. The over growth of antagonist is achieved when a fungus exhibits higher growth rate, tolerance against metabolites produced by the pathogens23 and capacity to produce antibiotics.
![]() |
Figure 3: Screening of Trichoderma species against R. solani by dual culture plate technique. |
![]() |
Figure 4: Trichoderma harzianum showing mycoparasitism over R. solani |
It is clear from the study that Azadirachta indica (neem oil) at 10 per cent concentration showed significant inhibition of mycelial growth of the pathogen. These results are in accordance with Singh et al. (1980) who studied the fungitoxic properties of plant extract against Rhizoctonia solani and reported that sclerotia formation in Rhizoctoni solani can be suppressed by Azadirachta indica. Similar results on antifungal activity of aqueous extracts of different plants have been reported by Rajput 2013 where neem oil extract were found to be effective as growth inhibitors. In present investigation mentha leaf extract and clove bud extract was not at all inhibitory to the pathogen even at 10% concentration.
Combining Seed Treatment with spray application improved the efficacy of treatments compared to seed treatment alone. Over the other treatments and the control, the Seed Treatment with T. harzianum+ spray of neem oil, produced the higher grain yield (90.9 percent) while both treatment with Neem oil application provide less grain yield as compared to other combination.
We therefore, conclude that management of this disease can be achieved by integrating seed or soil treatment by Trichoderma harzianum along with foliar application of neem oil.
Acknowledgment
We extend sincere thanks to DBT Star College Scheme, DBT, New Delhi for providing financial support for this work.
Conflict of Interest
There is no conflict of interest.
References
- Sharma, G. and Saxena, S.C. Integrated management of banded leaf and sheath blight of maize caused by Rhizoctonia solani (Kuhn) Advances in Plant Sci. 2002. 15: 107-113.
- Monfil V O, Casas-Flores S. Molecular mechanisms of biocontrol in Trichoderma spp. and their applications in agriculture. In: Gupta V G, Schmoll M, Herrera-Estrella A, Upadhyay R S, Druzhinina I, Tuohy M, eds., Biotechnology and Biology of Trichoderma . 2014.Elsevier Press, Amsterdam. pp. 429–45.
CrossRef - Boukaew S, Klinmanee C, Prasertsan P. Potential for the integration of biological and chemical control of sheath blight disease caused by Rhizoctonia solani on rice. World J. of Microbiol.and Biotech. 29, 1885–1893.
CrossRef - Madhavi, G.B., Bhattiprolu, S.L., Bharathi, S., Reddy, V.C. and Ankaiah, R. Studies on the management of banded leaf and sheath blight disease of maize (Rhizoctonia solani f. sp. sasakii) using fluorescent Pseudomonads. In: Proc. 2nd Asian PGPR Conference, Beijing P.R. China, 2011. pp 567-576.
- Izhar, T., and Chakraborty, M. Genetic analysis of banded leaf and sheath blight resistance (Rhizoctonia solani) in maize. of Pharmacognosy and Phytochemistry. 2013. 1: 1-5.
- Gao, J., Chen, Z., Luo, M., Peng, H., Lin, H., Qin, C., Yuan, G., Shen, Y., Ding, H., Zhao, M., Pan, G. and Zhang, Z. Genome expression profile analysis of the maize sheath in response to inoculation to solani, Mol. Biol. Rep. 2014. 41: 2471-2483.
CrossRef - Gopireddy, B.M., Uma Devi, G., Vijayakrishna K., Ramesh Babu, T. and Naidu, T.C.M. Cultural and Morphological Characterization of Rhizoctonia solani f. sp. sasakii Isolates Collected from Different Districts of Andhra Pradesh. J.Curr.Microbiol.App.Sci. 2017. 6(11): 3457-3469.
CrossRef - Bunker, R.N., Trivedi , A. and Mathur, K. Integrated management of banded leaf and sheath blight of maize caused by Rhizoctonia solani f.sp. sasakii. Journal of Mycology and Plant Pathology. 42(3): 367-317.
- Jones, R. K., Belmar, S. B. and Jeger, M. J. Evaluation of benomyl and propiconazole for controlling sheath blight of rice caused by Rhizoctonia solani. Plant Dis. 70 : 222-225.
CrossRef - Singh, R. D. and Kaiser, S. A. Evaluation of some systemic and nonsystemic fungicides against the charcoal rot pathogen Macrophomina phaseolina (Tassi) Goid. of maize. Tropical Agri. 1995. 33: 54-58.
- Rajput L.S., Harlapur S.I., Venkatesh, I., Aggarwal, S.K., Choudhary, M. In -vitro study of fungicides and an antibiotic against Rhizoctonia solani f. sp. sasakii causing banded leaf and sheath blight of maize. International Journal of Agriculture Sciences. 2016. 8(54), 2846–2848.
- Madhavi, P. Narayan Reddy , K. Manohar and Ch. Aruna Kumari. Effect of Fungicides and Herbicides against Rhizoctonia solani f. sp. sasakii Exner Causing Banded Leaf and Sheath Blight in maize (Zea mays L.). Int. J. of Bio-resource and Stress Management 2018, 9(1):142-153
CrossRef - Arora, S.A., Parminder S.K., 2009. Evaluation of plant extracts against Rhizoctonia solani causing sheath blight of rice. The J. of Plant Protec.Sci. 2009.1(1): 25-30.
- Divya Rani, V., Narayan Reddy, P. and Uma Devi, G.. Banded leaf and sheath blight of maize incited by Rhizoctonia solani f.sp. sasakii and its management. A review. J. of Appl.Biol. and Pharmaceutical Techn. 2013. 4: 52-60.
- Singh, U. P. M., Singh, H. B. and Singh, R. B. Effect of plant extract on growth of Rhizoctonia spp. Mycologia. 1980. 72 : 1077-1093.
CrossRef - Elad Y, Chet I, Katan Y. Trichoderma harzianum a biocontrol agent effective against Sclerotium rolfsii and Rhizoctonia solani. Phytopathol. 1980. 70: 119-121.
CrossRef - Sivan, A. and Chet, I. Degradation of fungal cell walls by lytic enzymes of Trichoderma harzianum. Gen Microbiol. 1989. 135: 675-682.
CrossRef - Gardener, B. B. M., & Fravel, D. R. Biological control of plant pathogens: research, commercialization, and application in the USA. Plant Health Progress. 2002. 3(1), 17.
CrossRef - Singh R., Maurya S., and Upadhyay R. S. Antifungal potential of Trichoderma species against Macrophomina phaseolina. of Agri. Techn. 2008: 1925-1933.
- Skidmore, A. M. and Dickinson, C. H. Colony interaction and hyphal interference between Sepatoria nodorum and phylloplane fungi. Br. Mycol. Soc. 1976. 66: 57-64.
CrossRef - Whipps, J.M. and Magan, N. Effects of nutrient status and water potential of media on fungal growth and antagonist-pathogen interactions. Bulletin OEPP/EPPO Bulletin. 1987. 17: 581-591.
CrossRef - Upadhyay R.S and Rai, B. Studies on antagonism between udum Butler and root region microflora of pigeonpea. Plant and Soil. 1987.101: 79-93.
CrossRef - Mathivanan, N., Srinivasan, K., Chelliah, S. Biological control of soil-borne diseases of cotton, eggplant, okra and sunflower by Trichoderma viride. Plant Dis. Prot. 2000. 107: 235–244.